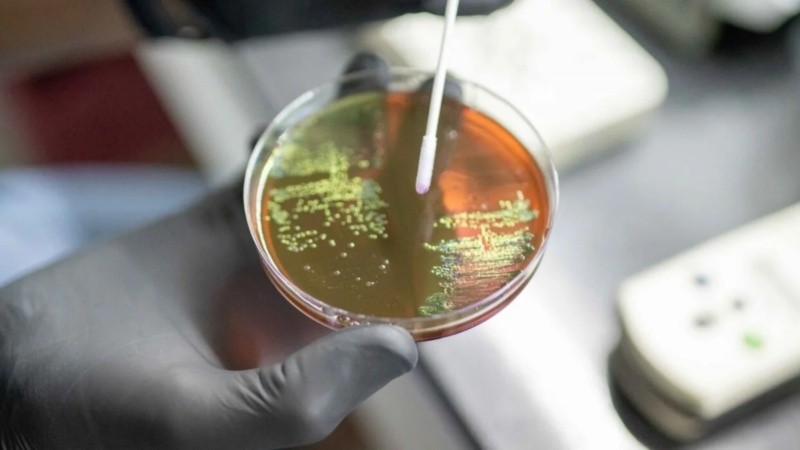
Una de las principales conclusiones refiere a que se necesitan de manera urgente nuevos agentes innovadores contra infecciones graves.

El pasado 14 de junio, la Organización Mundial de la Salud (OMS) publicó su último informe respecto de los agentes antibacterianos, entre ellos los antibióticos, que se encuentran en pleno desarrollo clínico y preclínico a escala mundial.
Si bien se informó que se incrementó el número de agentes antibacterianos en fase de desarrollo clínico (de 80 en 2021 a 97 en 2023), se necesitan de manera urgente nuevos agentes innovadores contra infecciones graves, lo que también ayudaría a sustituir a aquellos que perdieron eficacia por su uso generalizado.
Desarrollo de antibacterianos
Este tipo de informes se realiza en forma anual desde 2017 y, en el mismo, se evalúa si los antibióticos que actualmente están en fase de investigación y desarrollo (I+D) son eficaces para tratar infecciones causadas por bacterias farmacorresistentes, incluso las más peligrosas para la salud de los seres humanos. Las mismas también son descriptas en la Lista OMS de patógenos bacterianos prioritarios que se publican anualmente.
Ambos documentos guían la I+D antibacteriana, con el objetivo de hacer frente en mejores condiciones a la amenaza creciente de la resistencia de antimicrobianos (RAM). La RAM surge cuando las bacterias, los virus, los hongos y los parásitos dejan de responder a los medicamentos, lo que hace que las personas enfermen más e incrementa el riesgo de propagación de infecciones que son difíciles de tratar, de enfermedades y muerte.
La RAM se debe en gran medida al uso indebido y excesivo de los antimicrobianos, aunque, paradójicamente, muchas personas en todo el mundo no tienen acceso a medicamentos antimicrobianos esenciales.
"La resistencia a los antimicrobianos va a peor, pero no estamos desarrollando nuevos productos de vanguardia a la velocidad requerida para combatir las bacterias más peligrosas y letales", señaló la Dra. Yukiko Nakatani, Subdirectora General interina de la OMS para Resistencia a los Antimicrobianos. Y añadió: "La innovación brilla por su ausencia, pero incluso cuando se autorizan nuevos productos, surge el gran problema del acceso. Sencillamente, los agentes antibacterianos no llegan a los pacientes que los necesitan urgentemente, en países de todos los niveles de ingreso".
No solo hay demasiados pocos antibacterianos en fase de desarrollo, teniendo en cuenta el tiempo que requiere la I+D y la probabilidad de fracaso, sino que no se innova lo suficiente. De los 32 antibióticos en fase de desarrollo contra las infecciones de la Lista OMS de patógenos bacterianos prioritarios, solo 12 pueden considerarse innovadores. Además, solo cuatro de esos 12 son eficaces contra al menos 1 patógeno considerado "crítico" por la OMS. Hay lagunas en toda la fase de desarrollo, en particular en productos para niños, formulaciones orales más convenientes para pacientes ambulatorios y agentes contra el aumento de la farmacorresistencia.
Sin embargo, no deja de ser alentador que los agentes biológicos no tradicionales (bacteriófagos, anticuerpos, agentes antivirulencia, agentes inmunomoduladores y agentes moduladores del microbioma) se exploren cada vez más como complementos y alternativas a los antibióticos. De todas formas, estudiar y regular los agentes no tradicionales no es sencillo. Se necesitan más esfuerzos para facilitar la realización de estudios clínicos y evaluaciones de dichos productos, a fin de determinar cuándo y de qué modo utilizarlos en la práctica clínica.
Los antibacterianos recientemente aprobados
En cuanto a los antibacterianos recientemente aprobados, 13 nuevos antibióticos han obtenido autorización de comercialización desde el 1 de julio de 2017, pero solo dos de ellos constituyen una nueva clase de producto químico y pueden considerarse innovadores, lo que subraya el desafío científico y técnico de descubrir nuevos antibacterianos que sean, a la vez, eficaces contra las bacterias y seguros para los seres humanos.
Además, se han autorizado tres agentes no tradicionales, todos ellos productos de base fecal para restaurar la microbiota intestinal y prevenir la infección recurrente por Clostridioides difficile tras el tratamiento antibiótico en adultos.
La fase de desarrollo preclínico se revela activa e innovadora, con muchos enfoques no tradicionales, como parte de un número estable de candidatos preclínicos en los últimos cuatro años. La investigación sigue centrada principalmente en los patógenos gramnegativos, que son resistentes a los antibióticos de último recurso. Las bacterias gramnegativas tienen capacidades innatas para encontrar nuevas formas de resistir el tratamiento y pueden transmitir material genético que permite a otras bacterias ser también farmacorresistentes.
El giro hacia agentes antibacterianos que actúan contra un solo patógeno parece haberse estancado. Estos agentes incrementan la necesidad de diagnósticos rápidos que estén ampliamente disponibles y tengan precios asequibles, para garantizar que las bacterias pertinentes estén presentes en las infecciones que se van a tratar. Una mayor transparencia en la fase de desarrollo facilitaría la colaboración en proyectos potencialmente innovadores pero complejos, ayudaría a los científicos y desarrolladores de fármacos, y generaría más interés y fondos para el desarrollo de fármacos destinados a nuevos agentes antibacterianos.
El desarrollo de nuevos agentes antibacterianos debe ir acompañado de iniciativas en paralelo para garantizar un acceso equitativo, especialmente en los países de ingreso bajo y mediano. El acceso universal a herramientas asequibles y de calidad para prevenir, diagnosticar y tratar las infecciones es crucial para mitigar el impacto de la resistencia a los antimicrobianos en la salud pública y en la economía, según se indica en las Prioridades estratégicas y operacionales de la OMS para hacer frente a la resistencia a los antimicrobianos en el sector de la salud humana, la resolución sobre la RAM adoptada por la 77.ª Asamblea Mundial de la Salud y la publicación titulada "Un enfoque centrado en las personas para combatir la RAM y el conjunto básico de intervenciones contra la resistencia a los antimicrobianos".
Fuente: WHO/OMS.